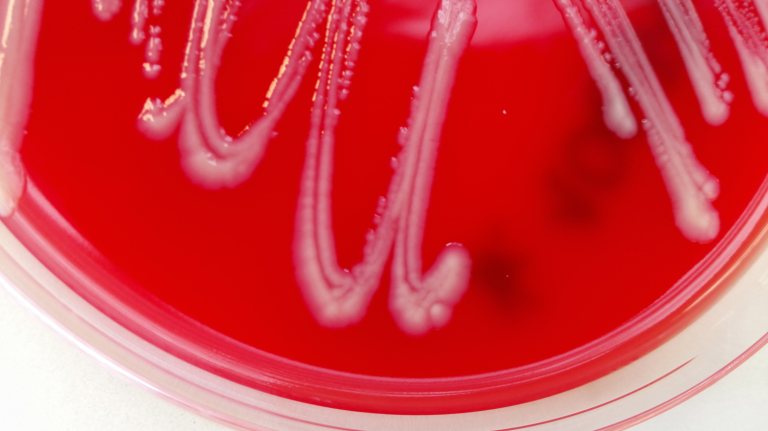
IMG_20180320_163437 foto Snorre Gulla2

Stort steg for bekjempelse av yersinose hos laksefisk
En ny metode gjør det enklere å spore, forebygge og bekjempe fiskesykdommen yersiniose.
For å bekjempe en sykdom, er det viktig å forstå hvordan den sprer seg. Nå har Veterinærinstutettet utviklet en ny sporingsmetode som gjør det mulig å vise hvordan fiskesykdommen yersiniose har spredd seg i oppdrettsnæringen.
Stort steg i kampen mot sykdommen
Metoden som også benyttes innen rettsmedisin kalt MLVA, gir en helt ny innsikt i og forståelse av smitteveier for fiskebakterien Yersinia ruckeri, som gir alvorlig sykdom hos oppdrettet laksefisk verden over.
— Vi ser nå at Y. ruckeri har forskjellig populasjonsstruktur og spredningsmønster rundt om i verden, sier Snorre Gulla, forsker ved Veterinærinstituttet. Gulla og hans kollegaer har fremskaffet resultater som springer ut fra et prosjekt finansiert av Fiskeri- og havbruksnæringens forskningsfond (FHF), og har omfattet nær 500 isolater av Y. ruckeri fra ulike verdensdeler og fiskearter.
— Den nylig utviklede metoden gjør det mulig å skille mellom ulike genetiske grupper av bakterien. Dette gir oss et nytt bilde av hvordan sykdommen har spredd seg ulikt innen oppdrettede populasjoner av henholdsvis regnbueørret og laks, forklarer han.
Mens sykdommen internasjonalt er et problem hovedsakelig i oppdrett av regnbueørret, sees utbruddene i Norge nærmest utelukkende hos atlantisk laks.
Viktig for smitteforebyggende tiltak
Gulla sier at funnene er svært viktige fordi det nå er enkelt å skille mellom stammer som tidligere fremsto som identiske. Studien viser også at serotypingsystemet som har vært brukt frem til nå har liten verdi for å spore hvor smitte kommer fra.
Den nye metoden representerer et enkelt verktøy for finskala smittesporing. Dette vil være relevant både for vaksineutvikling og implementering av andre smittereduserende tiltak, forklarer han.
Vil unngå «regnbueørret-varianten»
I Norge er yersiniose i dag utelukkende et problem hos oppdrettslaks og forekommer ikke innen oppdrett av regnbueørret.
— Funn av den spesielle «regnbueørret- varianten» i blant annet Storbritannia og store deler av kontinental-Europa (inkludert Sverige), men ikke i Norge, tyder på at vi bør være oppmerksomme på dette. En introduksjon til Norge kan bli alvorlig, sier Gulla.
Forskningsresultatene er tilgjengelig i tidsskriftet Applied and Environmental Microbiology.
Nytt prosjekt
I et nyoppstartet prosjekt vil MLVA-metoden bidra til å undersøke videre hvordan dagens yersiniose-situasjon best kan begrenses i Norge.
Forskningen fokuserer særlig på sjøfasen og ledes av Veterinærinstituttets Duncan J. Colquhoun og er et FHF-prosjekt.
Fakta MLVA:
- MLVA står for Multi Locus Variable number tandem repeat Analysis.
- Metoden er utviklet ved Veterinærinstituttet og benyttes også i rettsmedisin.
- Den gjør det mulig å skille undergrupper av bakterien Yersinia ruckeri som tidligere fremsto som identiske.